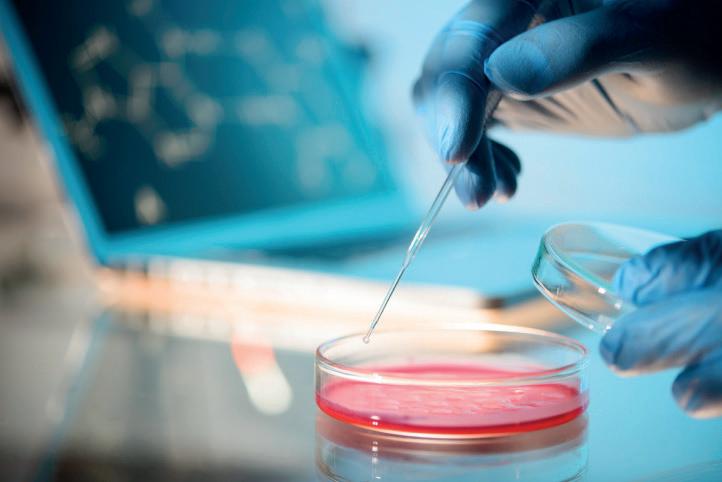

1 minute read
Evaluation
The Animal and Environment AMR Delivery Group for Wales has been established to refine and recommend the Animal and Environment AMR Implementation Plan for Wales. And to ensure that the Implementation Plan is delivered and its outcomes are achieved. The Implementation Plan outlines priorities, how these contribute to the strategic outcomes, and key actions. The plan will be kept under review.
If necessary, new priorities can be included to reflect situations, which may occur. It is expected that some priorities will remain in place over a number of years whilst others may have a much shorter lifespan but nevertheless can have considerable impact.
The priorities and the timeline for delivery of each objective will be considered by the Delivery Board. Every objective must be measurable so that success can be monitored.
Mae’r ddogfen yma hefyd ar gael yn Gymraeg. This document is also available in Welsh.